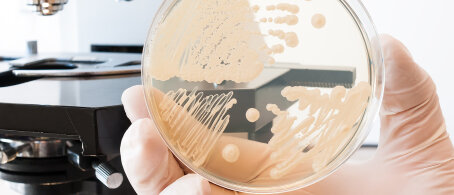

Haut
BAKTERIEN IN DER CREME
Seite 1/1 3 Minuten
Ein neuer Stern am Pflegehimmel ist geboren. Wunderwaffe sind hier hauptsächlich Milchsäurebakterien, die man sonst eher aus dem Naturjoghurt kennt. Noch ist das Sortiment dieser Pflegeprodukte überschaubar und eine kleine Nische. Doch Experten gehen davon aus, dass sich dieser Beautytrend weiterentwickeln und etablieren wird. Prä- und Probiotika, also lebende Bakterien und Stoffe, die sie fördern, gibt es im Ernährungssektor schon lange.
Seit intensiv rund um die Darmmikrobiota geforscht wird, sind sie so ziemlich für jeden ein Begriff. So ist heute bekannt, dass ein gesundes Darmmilieu schützende Wirkungen vor Entzündungen, erhöhter Infektanfälligkeit, Lebererkrankungen, Typ-2-Diabetes, Krebs, Übergewicht, Allergien sowie neurologischen Erkrankungen hat. Auch das Hautbild kann sich durch eine ungesunde Darmflora oder zum Beispiel bei gastroenterologischen Erkrankungen wie Laktose- sowie Glutenintoleranz oder chronisch entzündlichen Darmerkrankungen wie Morbus Crohn oder Colitis Ulcerosa verschlechtern. Und selbst Akne und Rosazea können sich durch eine intakte Darmflora verbessern.
Der neuste Beauty-Trend sind Cremes mit Milchsäure-Bakterien oder Substanzen daraus. Damit soll die Immunabwehr angeregt werden.
Der Mensch ist, was er isst Der Verdauungstrakt und die Haut sind eng miteinander verknüpft. Gesund und besonders abwechslungsreich zu essen, mit wenig Zucker oder stark verarbeiteten Kohlenhydraten, ist also nicht nur wichtig für sämtliche Körperfunktionen, sondern tut auch der Haut gut. Es ist praktisch Hautpflege von innen. Erklären Sie Ihren Kunden, warum Prä- und Probiotika so wichtig und gesund sind. Probiotika sind lebende Mikroorganismen, beispielsweise Milchsäurebakterien, die sich im Darm ansiedeln. Dazu gibt es inzwischen eine Fülle an hochwertigen Nahrungsergänzungsmitteln. Im Hinblick auf probiotische Lebensmittel können Sie Ihren Kunden zum Beispiel Kefir, Naturjoghurt, Kimchi – ein scharfer, milchsauer vergorener Chinakohl-, milchsauer vergorene Bohnen oder fermentiertes Gemüse wie Sauerkraut empfehlen. Bei Präbiotika handelt es sich um Nahrungsmittel oder Inhaltsstoffe, die eine positive Wirkung auf Darmbakterien und damit verbunden die Darmgesundheit haben. Dazu zählt eine Fülle an Gemüse wie Lauch, Zwiebeln und Mais, sowie Bananen, Beerenobst, Hülsenfrüchte, aber auch Flohsamenschalen, Leinsamen, Akazienfasern, Pektin, Weizen- und Haferkleie sowie Xylit. Der Einsatz dieser Nahrungsergänzungsmittel macht besonders viel Sinn, wenn Kunden ein Antibiotikum einnehmen müssen. Denn dieses wirkt sich negativ auf die Darmbakterien aus. Empfehlen Sie hier direkt ein entsprechendes Synbiotikum (Kombination aus Prä- und Probiotikum) zum Antibiotikum dazu.
Mikroben in Cremes und Seren Eigentlich gilt es, Cremes und Co. vor Bakterien zu schützen. Deshalb gibt es sie in verschiedenen Spendern, die ihren Inhalt möglichst steril halten sollen. Doch bei probiotischer Kosmetik ist es anders, denn hier haben Bakterien eine positive Wirkung. So sollen sie für ein glatteres Hautbild sorgen und die Hautalterung drosseln. Bei allergischer, zu Irritationen neigender Haut, bei Akne und Rosazea kann sich das Hautbild durch probiotische Cremes verbessern, heißt es von Seiten der Hersteller. Die enthaltenen Bakterien sollen eine Art Schutzschild gegen Krankheitserreger von außen und gegen schädliche Umwelteinflüsse bilden.
Neue Wirkstoffe Nun haben sich auch Forscher des Themas Probiotika in der Kosmetik angenommen und ihre Wirkung zur Hautpflege untersucht. Besonderes Augenmerk lag hier auf der Hautalterung. Auch wenn dies ein natürlicher Prozess ist, können Umwelteinflüsse wie Sonne, ungünstige klimatische Bedingungen, Schad- und Reizstoffe, schädliche Mikroorganismen sowie Stress und ungesunde Lebensweise die Prozesse beschleunigen. Zur Stärkung der natürlichen Hautbarriere kann ein probiotischer Pflegestoff aus gesundheitsfördernden Bakterien in den tieferen Hautschichten die Hautbarriere von innen stärken. Im Fokus steht hier zum Beispiel der probiotische Wirkstoff Pro Renew Complex CLR. Dieser soll aktiv gegen umweltbedingte, vorzeitige Hautalterung wirken und zur Gesunderhaltung der Haut beitragen.
Möglichkeiten und Grenzen Noch sind solche Produkte wenig bekannt. Es ist aber nur eine Frage der Zeit, bis sämtliche Kosmetikhersteller die positiven Bakterien in ihre Hautpflegeserien integrieren. Begleitet wird dies dann mit Sicherheit von großen Werbekampagnen, um die Verbraucher für dieses neue Beautythema zu sensibilisieren. Derzeit wird in probiotischer Kosmetik nur bedingt auf lebende Bakterienkulturen zurückgegriffen. Alternativ verwenden Hersteller meist einzelne aus dem Bakterium extrahierte Stoffwechselprodukte dieser Bakterien. So ist die Frage noch offen, welches der unzähligen Bakterien nun das geeignetste zur effektiven Hautpflege ist.
Den Artikel finden Sie auch in die PTA IN DER APOTHEKE 10/19 ab Seite 108.
Kirsten Metternich von Wolff, Freie Journalistin